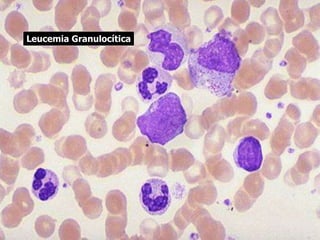
Leucemia Granulocítica
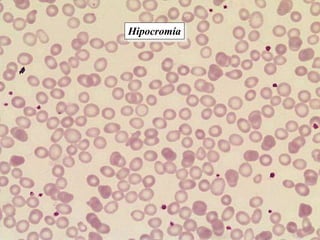
Hipocromía
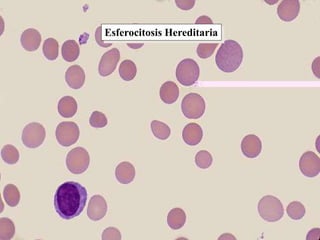
Esferocitosis Hereditaria

El documento presenta la lista de integrantes del Equipo No. 1 y luego describe brevemente las pruebas diagnósticas, incluyendo su propósito de ayudar a confirmar posibles diagnósticos, que suelen implicar estudios de laboratorio, y los principios que determinan el valor de una prueba como sensibilidad, especificidad, valor predictivo positivo y negativo. Finalmente, presenta un cuadro sobre la clasificación de los resultados verdaderos y falsos de una prueba.